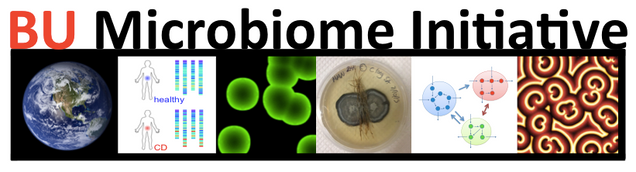

BU Microbiome redirect
You are being re-directed to the new BU microbiome homepage (http://microbu.org)
Welcome to the Boston University Microbiome Initiative. We bring together scientists from different disciplines and departments, with a common interest in microbial ecosystems. Our research spans multiple scales and levels of complexity, with applications in global change, metabolic engineering and biomedicine.
More information about our initiative will be available soon. In the meantime, we are excited to announce our first
BU Microbiome Day
a mini-symposium, sponsored by the Boston University Interdisciplinary Biomedical Research office (IBRO) and by the Kavli Foundation.
The symposium will take place on
February 16, 2017, in LSEB 103
(24 Cummingtom Mall, Boston)
Registration is now closed, as the number of registered participants exceeds the seating capacity of our seminar room.
Agenda:
8:30 Breakfast and Registration
9:00 Introductory Remarks (Gloria Waters, BU Vice President and Associate Provost for Research; Daniel Segrè, BU Biology and Bioinformatics)
9:15 Keynote Talk: Michael Travisano (Dept. of
Ecology, Evolution, and Behavior, University of Minnesota) – Sources of Complexity in Microbial Ecology
10:00 Kirill Korolev (BU Physics and Bioinformatics) – Statistical Physics of Microbial Communities
10:15 Allyson Sgro (BU Biomedical Engineering) – Robustness in Microbial Collective Behavior
10:30 Coffee Break
11:15 Keynote Talk: Wenying Shou (Fred Hutchinson Cancer Center) – Synthetic communities: What can we learn from them?
12:00 Jennifer Talbot (BU Biology and Bioinformatics) – Systems biology of the Earth microbiome
12:15 Evan Johnson (BU Medicine, Biostatistics and Bioinformatics) – Integrating microbial and host transcriptomics to characterize asthma-associated microbial communities
12:30 Lunch and Poster Session
1:30 Roundtable Discussion Groups and Kavli Cakes
2:15 Closing Remarks and Poster Prize Presentation
Registration is now closed.
Location: LSEB 103 / 24 Cummington Mall
Questions? bioinfo@bu.edu